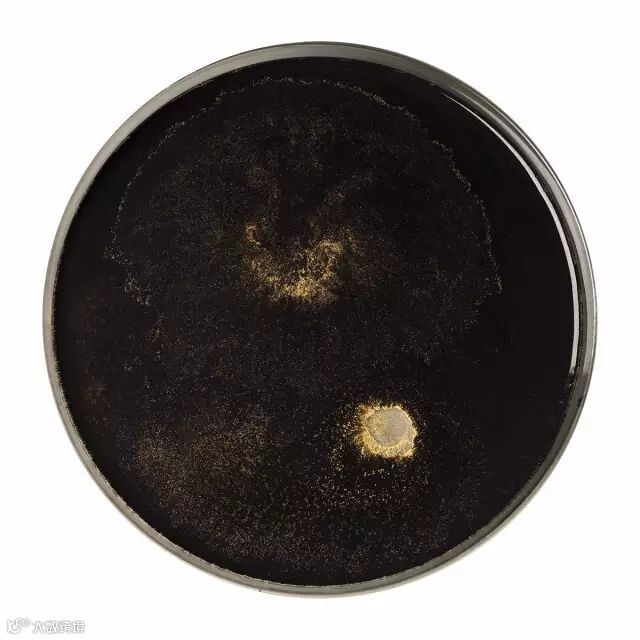

▽
德国 | studio inbetween




以色列 | Doria JD

波兰 | Ala Sieradzka








匈牙利 | Anett Safran





Anett 喜欢亲自去寻找制作盘子的陶土,甚至直接用岩石当食物的器皿,别有一番风味。



泰国 | Surasek Yutthiwat






《会说话的盘子》对不起、我爱你、很抱歉、生日快乐、不要放弃。。。简短的几个单词为用餐者带来触动心灵的感受。
盘子底部已经印好这些短句,只要拿配套的彩笔在上面涂抹,文字就会立马显现出来,这个盘子真是太浪漫了~



乌克兰 | Andre Burbela
世界粮食计划署WPP《饥饿》







△

优得配-工艺配件助手!
微信&手机:13655911461!



